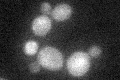
YOR061W
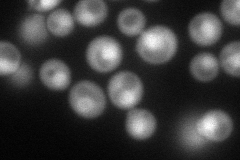
YOR061W
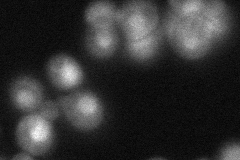
YOR061W
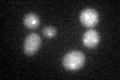
YOR061W
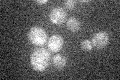
YOR061W

View description
Alpha' catalytic subunit of casein kinase 2, a Ser/Thr protein kinase with roles in cell growth and proliferation; the holoenzyme also contains CKA1, CKB1 and CKB2, the many substrates include transcription factors and all RNA polymerases
Localization:
Intensity:
Fold change:
Significance:
-
C’ GFP library in SD
nucleus:cytosol22.34 -
N' NOP1pr-GFP in SD
cytosol,nucleus125.496 -
N' TEF2pr-mCherry in SD

missing0 -
N' NATIVEpr-GFP in SD
nucleus56.2624 -
N' TEF2pr-VC and Cyto-VN in SD

#N/A0 -
C’ GFP library in SD+DTT
nucleus.cytosol21.630.96No -
C’ GFP library in SD+H2O2

nucleus.cytosol18.880.84No -
C’ GFP library in Starvation Media
nucleus,cytosol14.650.65Yes -
C’ GFP library on the background of Pup2-DaMP

nucleus:cytosol -
C’ GFP library on the background of CCT mutant

nucleus:cytosol22.37961.00166No
